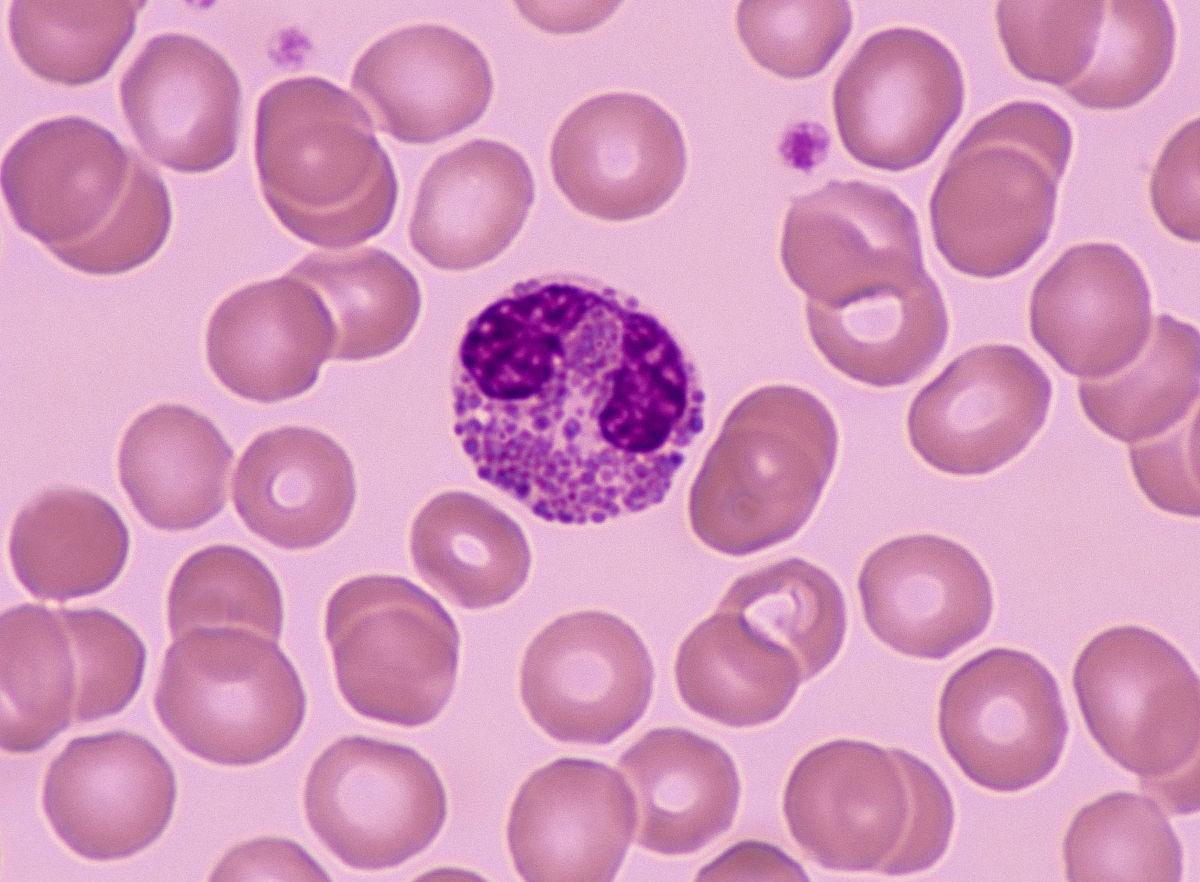
播散性嗜酸性粒细胞增多什么意思,嗜酸性粒细胞增多症血液病

导语:播散性嗜酸粒子细胞增多性胶原病,是一种变应性疾病,其特点是发热、呼吸道症状、肝脾肿大和周围嗜酸性粒细胞增多。病龄为6个月至47岁。男女患病比例为13:10。此病的具体病因还不清楚,临床多见全身酸痛,以及情绪烦躁等。
一、患有播散性嗜酸粒细胞增多性胶原病的原因是什么?临床表现多见发热,关节症状
1、病因
具体原因尚不清楚。因嗜酸性粒细胞增多、哮喘及血清免疫球蛋白 E (IGE)增高,有可能为 I型过敏反应。
2、临床表现
以疲劳、全身酸痛、食欲减退、烦躁不安、失眠为主。和其它胶原病一样,本病也有多系统损伤的特征。
(1)发热
实际上,所有的病例都有发热,并且大多数在发病期间。可以是松弛热或漏热,温度在38℃以上。
(2)关节症状
主要症状是关节炎或关节痛,有时可出现关节腔积液和肿胀。关节炎症状由轻到重,严重到活动受限,晨僵,但不会造成关节变形。能对全身关节产生影响,尤其是四肢,尤其是手。有一部分患者肌肉酸痛、无力。

(3)皮肤损伤
有几种类型的皮肤改变:红斑,多形性红斑;丘疹;皮炎,斑块,黄斑;坏死,疤痕;红皮病。一个疹子可以单独存在,也可以多种疹子并存或连续发生。最常见的早期皮肤改变是前额和躯干的粟粒性丘疹。随病程发展,可逐渐扩散到四肢,演变成*麻疹荨**样红斑、团状或过敏性皮炎样疹,并伴有严重瘙痒。初发性粟粒性丘疹也可迅速发展为全身皮肤红肿、增厚和脱屑,常伴有瘙痒,即所谓的红皮病样疹。有时候在四肢可伴有地衣样变化,在皮肤疾病逐渐消退后可伴有细网色素沉着。
(4)四肢出现粟粒丘疹
早期皮肤损伤也可表现为散布在全身边缘的红斑。红色斑点的大小从卵到掌心都有。色泽鲜红,中心色浅,稍高于皮肤。红色斑点与浅棕色色素混杂,常相互融合,形成斑块或黄瘤样改变。严重时可发生局部红斑坏死,消退后可留疤。人体不同部位有不同类型的皮损,如躯干红斑,多形渗出性红斑,四肢粟粒丘疹或过敏性皮炎等。总而言之,该病的皮肤变化多种多样,但其常见病特点为弥散、伴发痒。

(5)心肺症状
病人在发病时多有呼吸系统症状,有不同程度的咳嗽、喘息样呼吸困难、咳嗽样痰或粘液样痰,痰涂片显示嗜酸性粒细胞增多。因嗜酸性粒细胞浸润于肺组织而引起的短暂肺炎。因为长期应用糖皮质激素治疗可使机体抵抗力下降,极易继发细菌感染,最终导致支气管肺炎,加重病情甚至致死。
超过一半的病人心脏增大,但大多数人早期没有症状,后期可能出现充血性心衰。基本上所有病例均有窦性心动过速。心搏和体温分开。
(6)消化道症状
腹部疼痛、恶心、呕吐、偶尔腹泻或便秘,或两者兼而有之,可由胃肠内嗜酸性粒细胞浸润引起。超过半数的患者肝脾肿大。
(7)神经症状
有些病人可能有神经症状,如步态障碍,意识障碍,视力障碍,四肢瘫,上睑下垂,颅内压和病理反射。大约1/3的病人患有淋巴结病,其中淋巴结病可为全身或局部淋巴结病,尤其是颈部及腋下。

二、患有播散性嗜酸粒细胞增多性胶原病,可以通过血常规,以及血沉进行检查
1、血常规及血沉
可增加白细胞总数,但分类计数只有嗜酸性粒细胞,多为成熟期。活动期 ESR增高;
2、尿常规
可以有轻微的蛋白尿,镜下血尿或小管性尿,尿液变化一般是轻微的。
3、生化检查
可能存在轻微的肝功能异常,蛋白电泳可发现高的丙种球蛋白。

4、免疫学检查
血清 IgE及免疫球蛋白 G (IgG)均明显升高。其中2/3病人 RA阳性,1/5病人抗核抗体阳性。
5、胸部X线检查
大多数患者有不同程度的炎症,有时心脏扩大。单个病例可出现手畸形,关节腔狭窄,骨质破坏,偶有关节脱位或半脱位。
三、播散性嗜酸粒细胞增多性胶原病,依据临床症状,以及病理特征进行诊断,需要和结节性多动脉炎等进行鉴别
1、诊断方法
诊断应依据皮肤病变、临床表现、病理特征以及外周血嗜酸性粒细胞增多等多系统受累特征。
2、鉴别诊断
应排除下列伴随嗜酸性粒细胞增高的疾病
(1)结节性多动脉炎
内脏损伤以心、肾、神经系统损伤最多见,最重。病灶多为紫癜和结节,沿动脉分布,多数未见弥漫性瘙痒性粟粒丘疹或斑块。病变主要表现为纤维坏死性动脉炎,多数表皮和真皮胶原纤维无明显改变。RA和抗核抗体均为阴性。上述病理及实验室异常与弥散型嗜酸性胶原病不同。

(2)变应性肉芽肿
该病为肉芽肿性血管炎,累及多器官,以肺浸润为主,主要表现为哮喘,外周血嗜酸性粒细胞增多。病灶以皮肤或皮下结节及紫斑为主。病变为纤维素样坏死性血管炎,主要累及肌肉动脉,伴肉芽肿。皮下胶原纤维未改变。RA和抗核抗体均为阴性。
(3)韦格内肉芽肿
这是一种坏死性肉芽肿性脉管炎。气道、肾、眼等多见,常伴有上呼吸道骨质破坏。无粟粒性丘疹,无斑块,无皮肤胶原纤维改变。抗体均为阴性, IgE水平正常。
3、治疗
应用免疫*制剂抑**或糖皮质激素控制癫痫复发。因病情不能及时痊愈而需长期使用激素时,应采用小剂量隔日治疗。在用药期间,一旦肺部症状加重和持续高热,则提示继发肺部感染。在这个时候,需要足够有效的抗生素来控制感染。

4、预后
良性肿瘤,但常复发,可导致继发性肺部感染死亡。
结语:此病的男女患病比例大约是13:10 。患者的主要症状有发热,以及关节症状等。此病的主要检查方法有血常规检查,以及尿常规检查等。治疗多使用免疫*制剂抑**,或者是糖皮质激素等。此病的预后较好,发现患病,需要及时就医治疗。